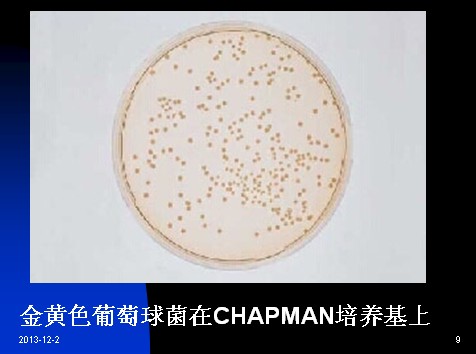

葡萄球菌食物中毒是由于食用了被葡萄球菌污染的食品所致,这种 食品能促进菌体的生长,从而产生毒素:在100℃加热30min不会破坏葡萄球菌毒素。所以,若通过镜检能观察到盐渍或腌制食品中含有大的金黄色葡萄球菌菌体,既使不是活菌体,也不能说这种食品安全。有些资料认为食品中盐的浓度能够抑制毒素的产生,但毒素能否生成还取决于食品的成分。现在已经有了在腌制食品中产生毒素的报道。
A、在B-P平板上:呈圆形,表面光滑、凸起、湿润,直径2~3mm。灰黑色至黑色,有光泽,常有浅色(非白色)的边缘,周围绕以不透明圈(沉淀),其外常有一清晰带(卵磷脂环)。当用接种针触及菌落时具有黄油样粘稠感。有时可见到不分解脂肪的菌株,除没有不透明圈和清晰带外,其他外观基本相同。从长期贮存的冷冻或脱水食品中分离的菌落,其黑色常较典型菌落浅些,且外观可能较粗糙,质地较干燥。
B、在血琼脂上:白色菌落,在其周围有溶血环。
C、金黄色葡萄球菌在CHAPMAN培养基上 :
D、金黄色葡萄球菌在甘露醇高盐琼脂培养基上:
黄色菌落,在其周围有黄色的环
E、金黄色葡萄球菌在DNA酶琼脂培养基上:
黑色菌落,在其周围有白色的环
F、金黄色葡萄球菌在Vogel-Johnson培养基上:
黑色菌落

上一篇:单核细胞增生李斯特菌的增菌检测方法
下一篇:非选择性培养基


 海博微信公众号
海博微信公众号
 海博天猫旗舰店
海博天猫旗舰店


 海博微信公众号
海博微信公众号
 海博天猫旗舰店
海博天猫旗舰店